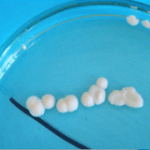

Dr. Paulina Altrych
-
General Surgery
-
Dermatology
-
Preventative Medicine
-
Internal medicine
BIOGRAPHY
Dr. Paulina was born and raised in the capital city of Warsaw, Poland. She enjoyed horseback-riding as a child and spent much of her time around animals. As time to enroll in college fast approached, Dr. Paulina decided that she would love to pursue a passion of hers, being something related to animals. In 2007 she graduated with honors from the Warsaw University of Life Sciences with a degree in Veterinary Medicine. After graduation she joined the Department of Preclinical Sciences, specifically the Parasitology, Bacteriology, and Mycology Division. It was in this field that Dr. Paulina conducted workshops for other students and defended her thesis. Around the same time, Dr. Paulina joined the veterinary medical team at the busy, 24 hour, Warsaw University Veterinary Clinic, working as an independent veterinarian.
Dr. Paulina decided to relocate to Dubai at the beginning of 2012. From 2014 to 2016 she completed 3 levels of extensive dermatology training at the European School for Advanced Veterinary Studies (ESAVS) in Luxembourg. Dr. Paulina is a member of ESVD (European Society of Veterinary Dermatology). Dr. Paulina very much enjoys horseback-riding and going to the beach during her time away from work.
PUBLICATIONS
Reader speaks to experts to highlight how allergies can be maintained